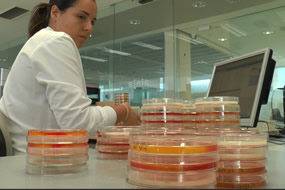

Suscríbete a nuestra newsletter
- Líneas I+D+i
- Servicios Tecnológicos
- Servicios Consultoría
- Servicios Laboratorio
- Formación y Eventos
- Sectores

Frente a los métodos microbiológicos convencionales, generalmente laboriosos, los avances tecnológicos han dado lugar a una amplia gama de métodos rápidos que son hoy los más utilizados, ante la demanda de resultados analíticos inmediatos.
La identificación de patógenos en alimentos por técnicas moleculares PCR plantea importantes ventajas:
Son técnicas altamente específicas para cada microorganismo, con gran sensibilidad y fiabilidad en la detección.
Son técnicas rápidas, capaces de ofrecer resultados en 24 horas, posibilitando así la liberación positiva de producto en periodos de tiempo cortos, con los consiguientes ahorros de costes al no tener producto retenido.
El gran reto de los métodos moleculares está en que no tienen protocolos estandarizados, por lo que se deben desarrollar a medida de cada matriz, algunas de gran complejidad, de ahí que no todos los laboratorios especializados en control de alimentos sean capaces de poderlas desarrollar.
En los laboratorios de control microbiológico de AINIA trabajamos con técnicas moleculares para el control de patógenos desde hace más de una década y tenemos un gran número de ensayos acreditados por ENAC para el control de patógenos por técnicas avanzadas de PCR. Para conocer cómo trabajan nuestros laboratorios en el control de patógenos y la problemática respecto al diagnóstico de los mismos, puede visualizar este vídeo:
También esta semana los laboratorios de AINIA han ampliado su acreditación ENAC para el control analítico de Salmonella Enteritidis y Typhimurium, mediante técnicas avanzadas por PCR, ampliando la oferta de ensayos acreditados en carnes frescas de aves de corral (gallinas, pollos, pavos…).
AINIA da así respuesta a las necesidades de las empresas avícolas de manera que los productores de este tipo de alimentos perecederos tienen respuesta analítica para poner en el mercado sus productos con las garantías de calidad higiénico-sanitarias adecuadas.
Dar la máxima cobertura a los parámetros y materias activas requeridas por la industria, disminuir los tiempos de entrega de resultados de control analítico y ofrecer los resultados más rigurosos son objetivos constantes de los laboratorios de AINIA. Si necesita un laboratorio experimentado y reconocido internacionalmente, cuente con nosotros.


| Responsable | AINIA |
| Domicilio | Calle Benjamín Franklin, 5 a 11, CP 46980 Paterna (Valencia) |
| Finalidad | Atender, registrar y contactarle para resolver la solicitud que nos realice mediante este formulario de contacto |
| Legitimación | Sus datos serán tratados solo con su consentimiento, al marcar la casilla mostrada en este formulario |
| Destinatarios | Sus datos no serán cedidos a terceros |
| Derechos | Tiene derecho a solicitarnos acceder a sus datos, corregirlos o eliminarlos, también puede solicitarnos limitar su tratamiento, oponerse a ello y a la portabilidad de sus datos, dirigiéndose a nuestra dirección postal o a privacy@ainia.es |
| Más info | Dispone de más información en nuestra Política de Privacidad |
| DPD | Si tiene dudas sobre como trataremos sus datos o quiere trasladar alguna sugerencia o queja, contacte al Delegado de protección de datos en info@businessadapter.es o en el Formulario de atención al interesado |
Consiento el uso de mis datos personales para que atiendan mi solicitud, según lo establecido en su Política de Privacidad
Consiento el uso de mis datos para recibir información y comunicaciones comerciales de su entidad.
